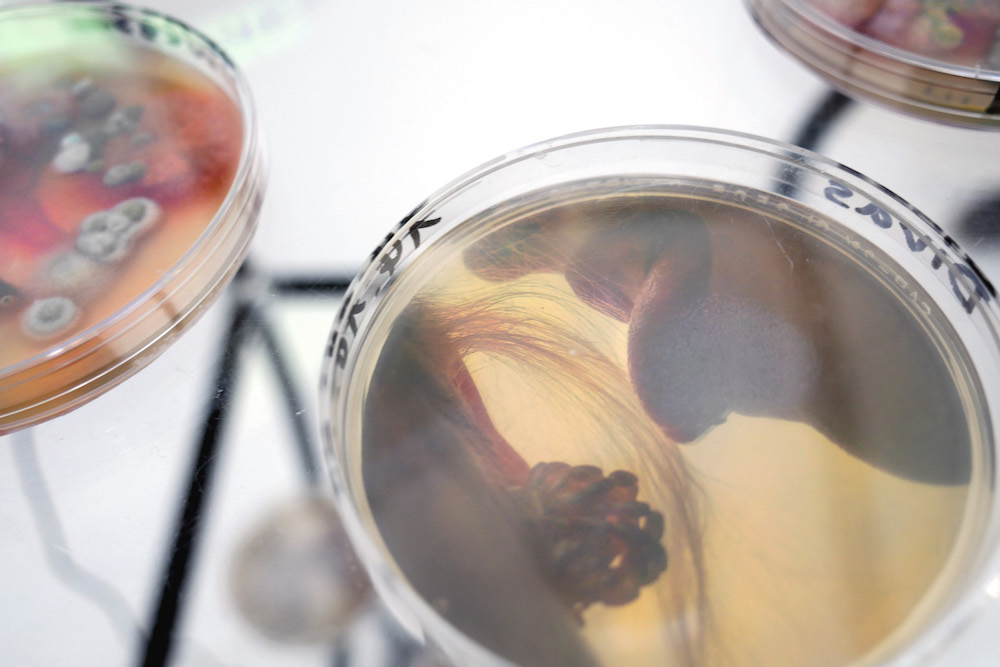

Zum Inhalt springen
Absolvent*innenausstellung ADBK Nürnberg 2018
„Showflakes“ in der Akademiegalerie Nürnberg 2017
„Apart“ im Museum Mitterteich mit Jennifer Danler 2015
„Ein gelegtes Brot“ in der Akademiegalerie Nürnberg, 2015
„In the Future 15 People willl be famous/ Prospekt (Retrospektive)“ im Neuen Museum Nürnberg 2012